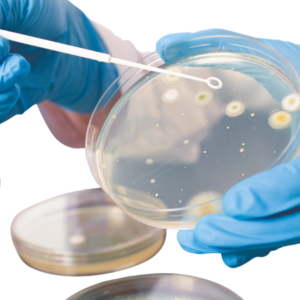
Sterile inoculation loops with high flexibility for uniform sample transfer in cell culture and laboratory applications

CULTURE DISH
Excellent Clarity
Uniform Surface treatment
Uniform growth surface
Different growth Areas available
TC Treated & Gamma Irradiation Sterile
Certified Dnase Rnase Free, Non Pyrogenic
Description
| Cat. No. | Description | Packing |
|---|---|---|
| MCCD17035 | 35mm Cell Culture Dish, 20Pcs./Pkg, TC Treated, Sterile | 500 |
| MCCD17060 | 60mm Cell Culture Dish, 20Pcs./Pkg, TC Treated, Sterile | 500 |
| MCCD10090 | 90mm Cell Culture Dish, 10Pcs./Pkg, Non Treated, Sterile | 500 |
| MCCD17090 | 90mm Cell Culture Dish, 10Pcs./Pkg, TC Treated, Sterile | 500 |
| MCCD17100 | 100mmCell Culture Dish, 5Pcs./Pkg, TC Treated, Sterile | 300 |
| MCCD17150 | 150mmCell Culture Dish, 5Pcs./Pkg, TC Treated, Sterile | 100 |